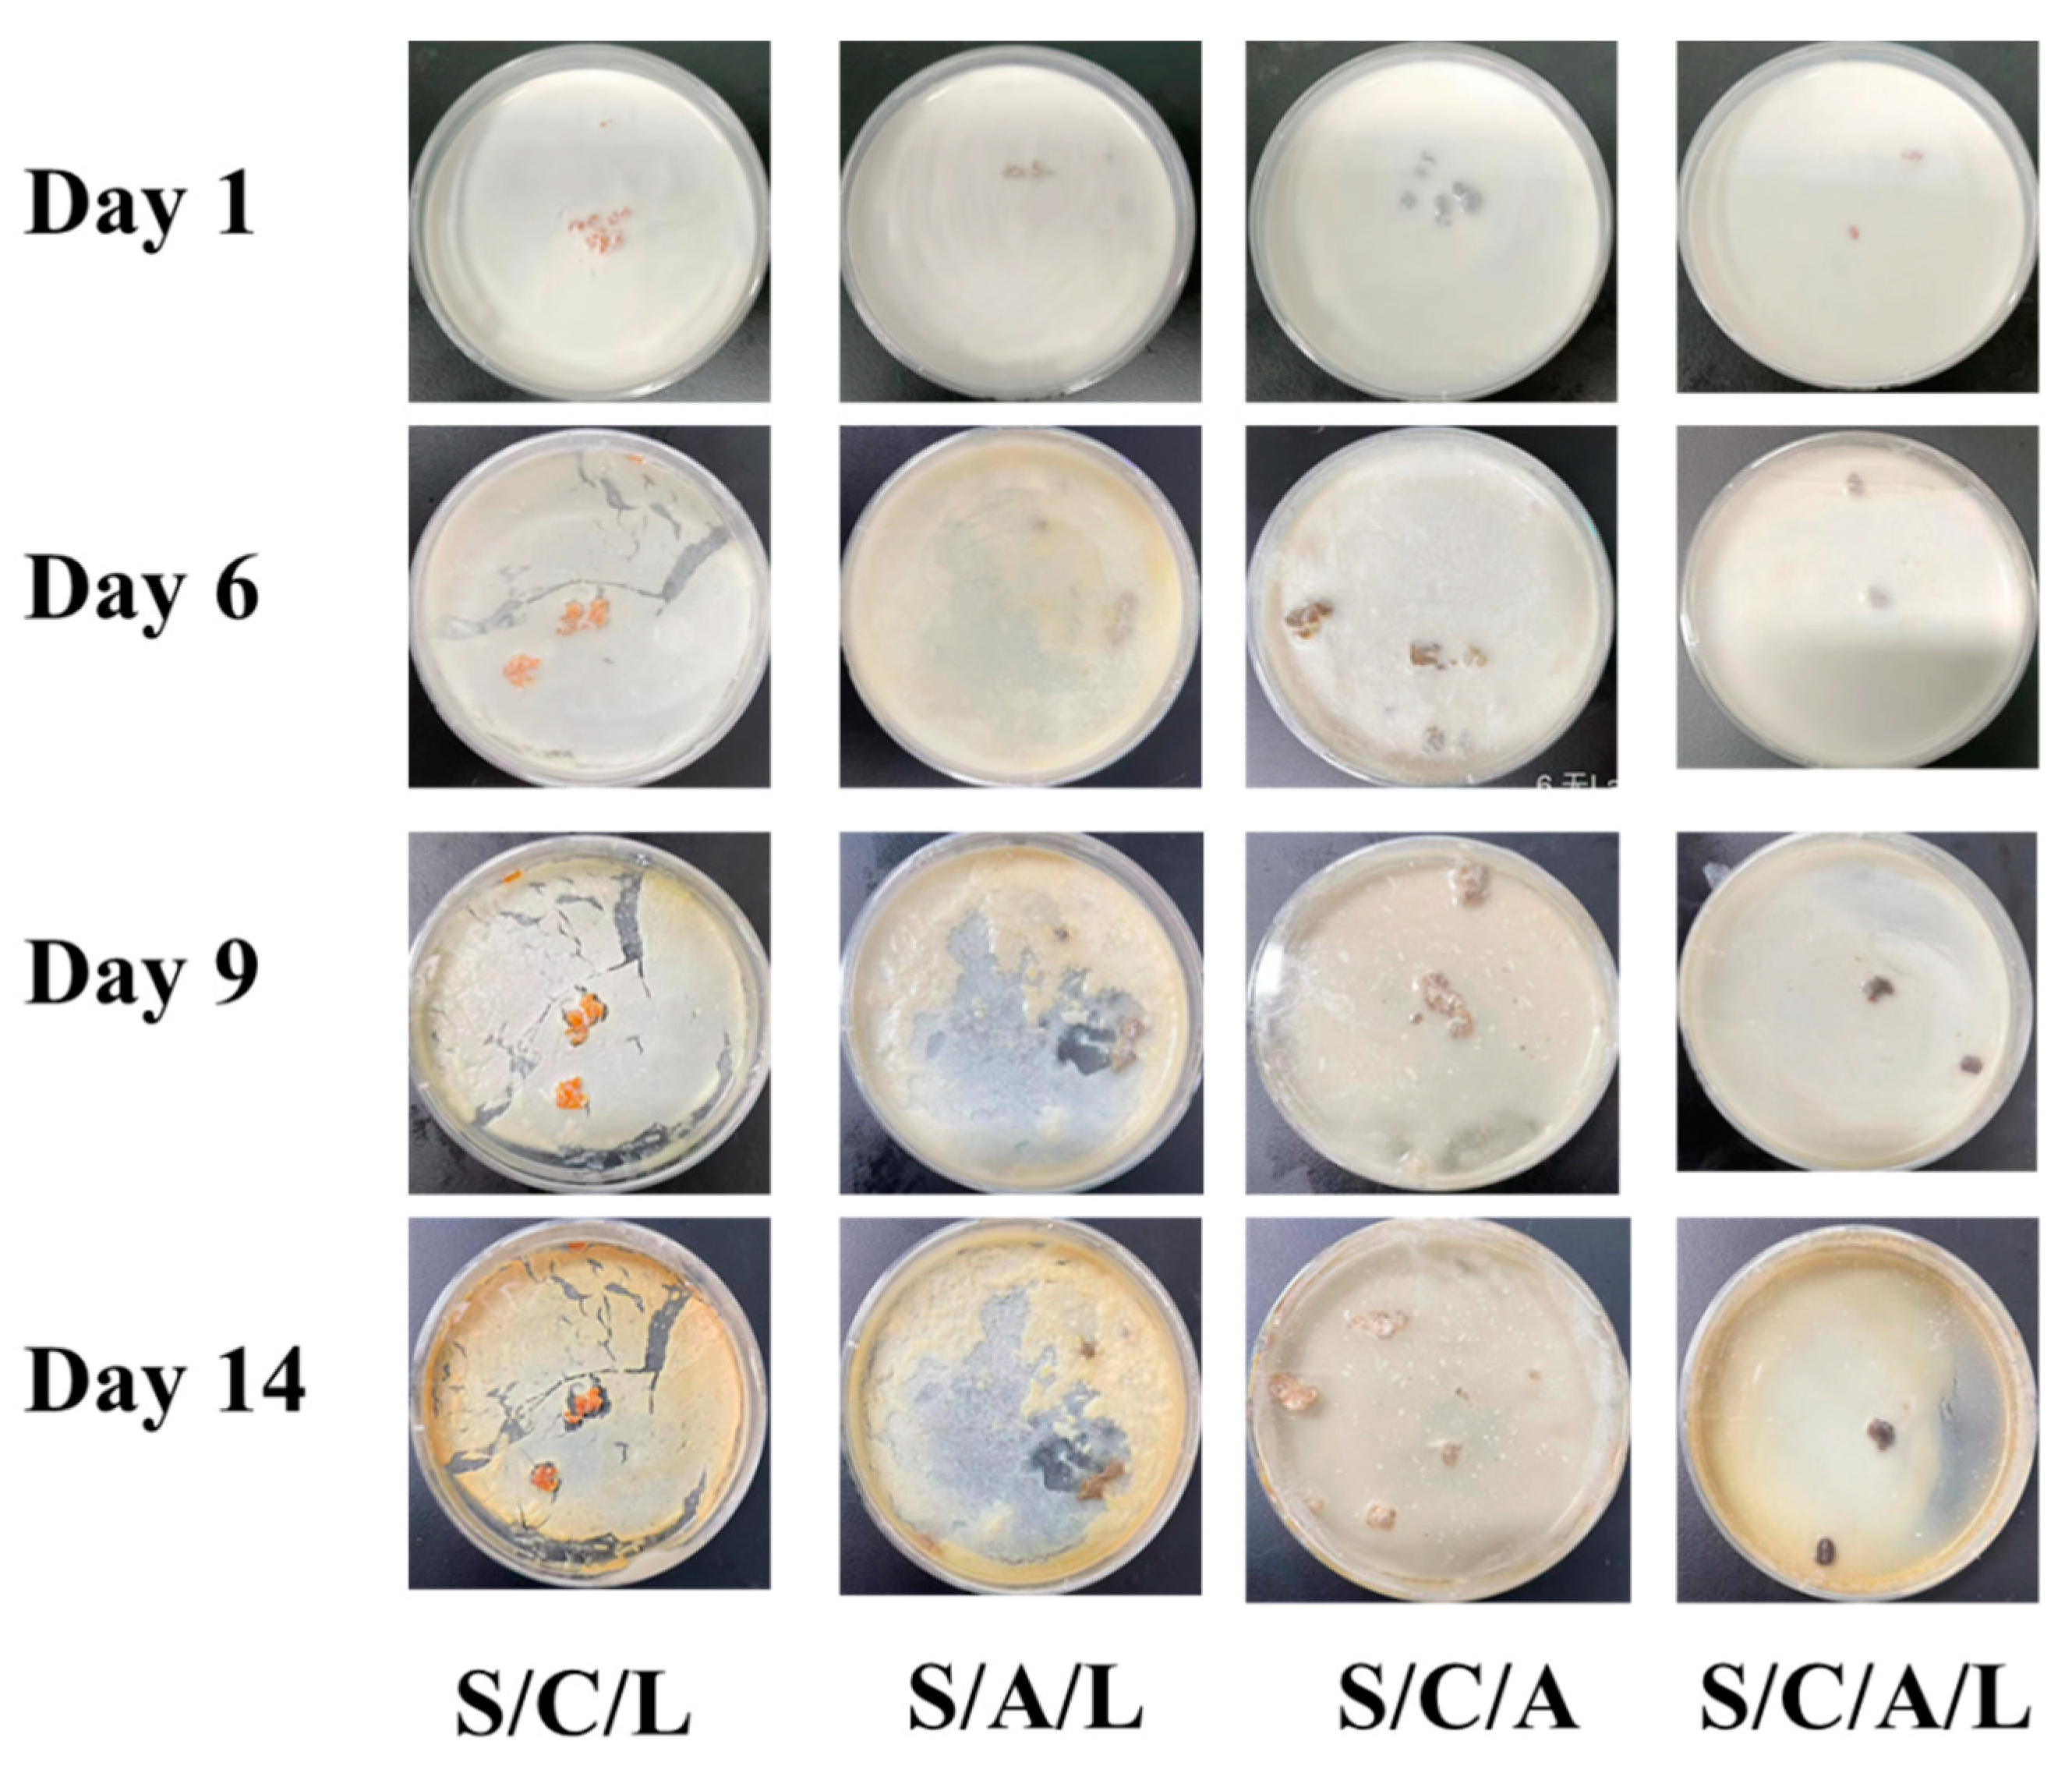
Processes 12 00662 g006

Sodium Alginate–Soy Protein Isolate–Chitosan–Capsaicin–Nanosilver Multifunctional Antibacterial Composite Gel
Abstract
1. Introduction
2. Materials and Methods
2.1. Materials
2.2. Pretreatment of Chili Peppers
2.3. Characterization of SA/SPI/CTS/CAP/Ag Gel
2.4. Antibacterial Property
2.5. SA/SPI/CTS/CAP/Ag Gel Preparation
2.6. Optimization of Gel Preparation Method and the Influence of Ag and CTS Dosage in SA/SPI/CTS/CAP/Ag Gel on Antibacterial Effect
2.7. Effect of C/CTS/PVA/CNF Hydrogel Dosage and Incubation Time
2.8. Antibacterial Reusability and Stability
2.9. Milk Antibacterial Simulation Experiment
2.10. Swelling Ratio, Water Loss, Moisture Adsorption, Moisture Content and of SA/SPI/CTS/CAP/Ag Gels
2.11. Degradation of SA/SPI/CTS/CAP/Ag Gels
2.12. Dye Adsorption with SA/SPI/CTS/CAP/Ag Gels
3. Result and Discussion
3.1. Characterization of SA/SPI/CTS/CAP/Ag Gel
3.2. Antimicrobial Property
3.2.1. Optimization of Gel Preparation Method and the Influence of Ag and CTS Dosage in SA/SPI/CTS/CAP/Ag Gel on Antibacterial Effect
3.2.2. Effect of SA/SPI/CTS/CAP/Ag Gel Dosage and Incubation Time
3.2.3. Stability and Reusability of SA/SPI/CTS/CAP/Ag Gel
3.2.4. Milk Antimicrobial Simulation Test
3.2.5. Synergistic Antibacterial Mechanism of SA/SPI/CTS/CAP/Ag Gel
3.3. Swelling Ratio, Water Loss, Moisture Adsorption, Moisture Content and of SA/SPI/CTS/CAP/Ag Gel
3.4. SA/SPI/CTS/CAP/Ag Gel Degradation
3.5. SA/SPI/CTS/CAP/Ag Gel Dye Adsorption Properties
4. Conclusions
Author Contributions
Funding
Institutional Review Board Statement
Informed Consent Statement
Data Availability Statement
Acknowledgments
Conflicts of Interest
References
- Xu, J.; Xu, Z. China sewage treatment engineering issues assessment. J. Clean. Prod. 2022, 377, 134391. [Google Scholar] [CrossRef]
- He, Q.; Zhang, H.; Ma, M.; He, Y.; Jia, J.; Hu, Q.; Gong, Y. Critical assessment of protozoa contamination and control measures in mass culture of the diatom Phaeodactylum tricornutum. Bioresour. Technol. 2022, 359, 127460. [Google Scholar] [CrossRef]
- Abdelaziz, M.A.; Owda, M.E.; Abouzeid, R.E.; Alaysuy, O.; Mohamed, E.I. Kinetics, isotherms, and mechanism of removing cationic and anionic dyes from aqueous solutions using chitosan/magnetite/silver nanoparticles. Int. J. Biol. Macromol. 2023, 225, 1462–1475. [Google Scholar] [CrossRef]
- Gopalakrishnan, S.; Kannan, P.; Balasubramani, K.; Rajamohan, N.; Rajasimman, M. Sustainable remediation of toxic congo red dye pollution using bio based carbon nanocomposite: Modelling and performance evaluation. Chemosphere 2023, 343, 140206. [Google Scholar] [CrossRef]
- Li, X.; Xu, L.; Gao, J.; Yan, M.; Bi, H.; Wang, Q. Surface modification of chitin nanofibers with dopamine as efficient nanosorbents for enhanced removal of dye pollution and metal ions. Int. J. Biol. Macromol. 2023, 253, 127113. [Google Scholar] [CrossRef]
- Xie, L.; Zhang, Z.; He, Y. Antibacterial Effect of Polyvinyl Alcohol/Biochar–Nano Silver/Sodium Alginate Gel Beads. Processes 2023, 11, 2330. [Google Scholar] [CrossRef]
- Zhang, Z.; He, Y. Synthesis and Characteristics of a Fish Scale-Based Biochar–Nanosilver Antibacterial Material. Processes 2023, 11, 1992. [Google Scholar] [CrossRef]
- Noguchi, M.; Aizawa, R.; Nakazawa, D.; Hakumura, Y.; Furuhashi, Y.; Yang, S.; Ninomiya, K.; Takahashi, K.; Honda, R. Application of real treated wastewater to starch production by microalgae: Potential effect of nutrients and microbial contamination. Biochem. Eng. J. 2021, 169, 107973. [Google Scholar] [CrossRef]
- El-Sherbiny, G.M.; El-Nour, S.A.A.; Askar, A.A.; Mohammad, N.H.; Hammad, A.A. Solar radiation-induced synthesis of bacterial cellulose/silver nanoparticles (BC/AgNPs) composite using BC as reducing and capping agent. Bioprocess Biosyst. Eng. 2021, 45, 257–268. [Google Scholar] [CrossRef]
- Hariram, M.; Vivekanandhan, S.; Ganesan, V.; Muthuramkumar, S.; Rodriguez-Uribe, A.; Mohanty, A.; Misra, M. Tecoma stans flower extract assisted biogenic synthesis of functional Ag-Talc nanostructures for antimicrobial applications. Bioresour. Technol. Rep. 2019, 7, 100298. [Google Scholar] [CrossRef]
- Poornima, H.; Srivastava, A.; Sharma, V.K.; Harikrishna; Kundu, A.; Singh, K.; Parihar, B.; Mangal, M. Assessing the retention of capsaicin and capsanthin compounds in chilli (Capsicum annuum L.) genotypes during storage. J. Food Compos. Anal. 2024, 127, 105948. [Google Scholar] [CrossRef]
- Mansalai, P.; Intanon, N.; Payaka, A.; Wattanalaorsomboon, S.; Chinvongamorn, C.; Sansenya, S. Inhibition potential against acetylcholinesterase of commercial and extracts of capsaicin and dihydrocapsaicin by in vitro and in silico studies. Process. Biochem. 2024, 136, 341–350. [Google Scholar] [CrossRef]
- Nolden, A.A.; Lenart, G.; Spielman, A.I.; Hayes, J.E. Inducible desensitization to capsaicin with repeated low-dose exposure in human volunteers. Physiol. Behav. 2024, 275, 114447. [Google Scholar] [CrossRef]
- Hunter, S.R.; Beatty, C.; Dalton, P.H. More spice, less salt: How capsaicin affects liking for and perceived saltiness of foods in people with smell loss. Appetite 2023, 190, 107032. [Google Scholar] [CrossRef] [PubMed]
- Pan, H.; Jiang, B.; Chen, J.; Jin, Z. Blend-modification of soy protein/lauric acid edible films using polysaccharides. Food Chem. 2014, 151, 1–6. [Google Scholar] [CrossRef] [PubMed]
- Feng, K.; Hung, G.-Y.; Yang, X.; Liu, M. High-strength and physical cross-linked nanocomposite hydrogel with clay nanotubes for strain sensor and dye adsorption application. Compos. Sci. Technol. 2019, 181, 107701. [Google Scholar] [CrossRef]
- Zolfagharian, S.; Zahedi, P.; Ardestani, M.S.; Khatibi, A.; Jafarkhani, S. Sodium alginate/xanthan-based nanocomposite hydrogels containing 5-fluorouracil: Characterization and cancer cell death studies in presence of halloysite nanotube. J. Ind. Eng. Chem. 2023, 120, 374–386. [Google Scholar] [CrossRef]
- Haleem, A.; Wu, F.; Ullah, M.; Saeed, T.; Li, H.; Pan, J. Chitosan functionalization with vinyl monomers via ultraviolet illumination under cryogenic conditions for efficient palladium recovery from waste electronic materials. Sep. Purif. Technol. 2024, 329, 125213. [Google Scholar] [CrossRef]
- Haleem, A.; Wu, F.; Wang, W.; Ullah, M.; Li, H.; Shah, A.; Pan, J. Fast and effective palladium adsorption from electronic waste using a highly macroporous monolith synthesized via rapid UV-irradiation. Sep. Purif. Technol. 2024, 331, 125500. [Google Scholar] [CrossRef]
- Salama, H.E.; Aziz, M.S.A. Non-toxic chitosan-pyrazole adsorbent enriched with greenly synthesized zinc oxide nanoparticles for dye removal from wastewater. Int. J. Biol. Macromol. 2023, 241, 124632. [Google Scholar] [CrossRef]
- Rath, A.; Grisin, B.; Pallicity, T.D.; Glaser, L.; Guhathakurta, J.; Oehlsen, N.; Simon, S.; Carosella, S.; Middendorf, P.; Stegbauer, L. Fabrication of chitosan-flax composites with differing molecular weights and its effect on mechanical properties. Compos. Sci. Technol. 2023, 235, 109952. [Google Scholar] [CrossRef]
- Guan, X.; Zhang, B.; Li, D.; Ren, J.; Zhu, Y.; Sun, Z.; Chen, Y. Semi-unzipping of chitosan-sodium alginate polyelectrolyte gel for efficient capture of metallic mineral ions from tannery effluent. Chem. Eng. J. 2023, 452, 139532. [Google Scholar] [CrossRef]
- López-Maldonado, E.A.; Oropeza-Guzmán, M.T. Synthesis and physicochemical mechanistic evaluation of chitosan-based interbiopolyelectrolyte complexes for effective encapsulation of OLZ for potential application in nano-psychiatry. Sustain. Chem. Pharm. 2021, 22, 100456. [Google Scholar] [CrossRef]
- Zhao, T.; Li, X.; Gong, Y.; Guo, Y.; Quan, F.; Shi, Q. Study on polysaccharide polyelectrolyte complex and fabrication of alginate/chitosan derivative composite fibers. Int. J. Biol. Macromol. 2021, 184, 181–187. [Google Scholar] [CrossRef] [PubMed]
- Tang, C.-H. Nanostructured soy proteins: Fabrication and applications as delivery systems for bioactives (a review). Food Hydrocoll. 2019, 91, 92–116. [Google Scholar] [CrossRef]
- Rahman, M.M.; Netravali, A.N. High-performance green nanocomposites using aligned bacterial cellulose and soy protein. Compos. Sci. Technol. 2017, 146, 183–190. [Google Scholar] [CrossRef]
- Luna-Sánchez, J.; Jiménez-Pérez, J.; Carbajal-Valdez, R.; Lopez-Gamboa, G.; Pérez-González, M.; Correa-Pacheco, Z. Green synthesis of silver nanoparticles using Jalapeño Chili extract and thermal lens study of acrylic resin nanocomposites. Thermochim. Acta 2019, 678, 178314. [Google Scholar] [CrossRef]
- Zhao, H.; Li, X.; Zhang, L.; Hu, Z.; Zhong, L.; Xue, J. Preparation and bacteriostatic research of porous polyvinyl alcohol/biochar/nanosilver polymer gel for drinking water treatment. Sci. Rep. 2021, 11, 12205. [Google Scholar] [CrossRef] [PubMed]
- Tantray, J.A.; Mansoor, S.; Wani, R.F.C.; Nissa, N.U. Chapter 43—Pour plate method for bacterial colony counting. In Basic Life Science Methods; Tantray, J.A., Mansoor, S., Wani, R.F.C., Nissa, N.U., Eds.; Academic Press: Cambridge, MA, USA, 2023; pp. 177–179. [Google Scholar]
- Kumar, A.; Negi, Y.S.; Bhardwaj, N.K.; Choudhary, V. Synthesis and characterization of methylcellulose/PVA based porous composite. Carbohydr. Polym. 2012, 88, 1364–1372. [Google Scholar] [CrossRef]
- Lin, D.; Kelly, A.L.; Maidannyk, V.; Miao, S. Effect of concentrations of alginate, soy protein isolate and sunflower oil on water loss, shrinkage, elastic and structural properties of alginate-based emulsion gel beads during gelation. Food Hydrocoll. 2020, 108, 105998. [Google Scholar] [CrossRef]
- Zhang, S.; Liu, C.; Yuan, Y.; Fan, M.; Zhang, D.; Wang, D.; Xu, Y. Selective, highly efficient extraction of Cr(III), Pb(II) and Fe(III) from complex water environment with a tea residue derived porous gel adsorbent. Bioresour. Technol. 2020, 311, 123520. [Google Scholar] [CrossRef] [PubMed]
- Zeng, H.; Sun, S.; Xu, K.; Zhao, W.; Hao, R.; Zhang, J.; Li, D. Iron-loaded magnetic alginate-chitosan double-gel interpenetrated porous beads for phosphate removal from water: Preparation, adsorption behavior and pH stability. React. Funct. Polym. 2022, 177, 105328. [Google Scholar] [CrossRef]
- Wang, Y.; Liu, D.; Liao, R.; Zhang, G.; Zhang, M.; Li, X. Study of adhesive self-degrading gel for wellbore sealing. Colloids Surf. A Physicochem. Eng. Asp. 2022, 651, 129567. [Google Scholar] [CrossRef]
- Zhang, Z.; He, Y.-C.; Liu, Y. Efficient antibacterial and dye adsorption by novel fish scale silver biochar composite gel. Int. J. Biol. Macromol. 2023, 248, 125804. [Google Scholar] [CrossRef] [PubMed]
- Xiang, X.; Yi, X.; Zheng, W.; Li, Y.; Zhang, C.; Wang, X.; Chen, Z.; Huang, M.; Ying, G.-G. Enhanced biodegradation of thiamethoxam with a novel polyvinyl alcohol (PVA)/sodium alginate (SA)/biochar immobilized Chryseobacterium sp H5. J. Hazard. Mater. 2023, 443, 130247. [Google Scholar] [CrossRef] [PubMed]
- Salunke, A.S.; Salunke, S.T.; Deokate, R.J.; Kale, B.B. Tuning of photoluminescence behavior of gold coated chitosan-polyvinyl alcohol binding with graphene quantum dots. Mater. Today Proc. 2022, 62, 1752–1757. [Google Scholar] [CrossRef]
- Wei, W.; Shang, N.; Zhang, X.; Liu, W.; Zhang, T.; Wu, M. A green 3-step combined modification for the preparation of biomass sorbent from waste chestnut thorns shell to efficient removal of methylene blue. Bioresour. Technol. 2022, 360, 127593. [Google Scholar] [CrossRef] [PubMed]
- Liang, W.; Zheng, J.; Saleh, A.S.; Zhao, W.; Liu, X.; Su, C.; Yan, M.; Ge, X.; Shen, H.; Ospankulova, G.; et al. Fabrication of biodegradable blend plastic from konjac glucomannan/zein/ PVA and understanding its multi-scale structure and physicochemical properties. Int. J. Biol. Macromol. 2023, 225, 172–184. [Google Scholar] [CrossRef] [PubMed]
- Xia, D.; Liu, Y.; Cheng, X.; Gu, P.; Chen, Q.; Zhang, Z. Temperature-tuned fish-scale biochar with two-dimensional homogeneous porous structure: A promising uranium extractant. Appl. Surf. Sci. 2022, 591, 153136. [Google Scholar] [CrossRef]
- Anusuya, N.; Pragathiswaran, C.; Mary, J.V. A potential catalyst—TiO2/ZnO based chitosan gel beads for the reduction of nitro-aromatic compounds aggregated sodium borohydride and their antimicrobial activity. J. Mol. Struct. 2021, 1236, 130197. [Google Scholar] [CrossRef]
- Wang, D.; Zhao, L.; Ma, H.; Zhang, H.; Guo, L.-H. Quantitative Analysis of Reactive Oxygen Species Photogenerated on Metal Oxide Nanoparticles and Their Bacteria Toxicity: The Role of Superoxide Radicals. Environ. Sci. Technol. 2017, 51, 10137–10145. [Google Scholar] [CrossRef] [PubMed]
- Xie, H.; Ouyang, K.; Zhang, L.; Hu, J.; Huang, S.; Sun, W.; Xiong, H.; Zhao, Q. Chitosan/rice hydrolysate/curcumin composite film: Effect of chitosan molecular weight. Int. J. Biol. Macromol. 2022, 210, 53–62. [Google Scholar] [CrossRef] [PubMed]
- Janani, B.; Okla, M.K.; Abdel-Maksoud, M.A.; AbdElgawad, H.; Thomas, A.M.; Raju, L.L.; Al-Qahtani, W.H.; Khan, S.S. CuO loaded ZnS nanoflower entrapped on PVA-chitosan matrix for boosted visible light photocatalysis for tetracycline degradation and anti-bacterial application. J. Environ. Manag. 2022, 306, 114396. [Google Scholar] [CrossRef] [PubMed]
- Hu, Z.; Zhang, L.; Zhong, L.; Zhou, Y.; Xue, J.; Li, Y. Preparation of an antibacterial chitosan-coated biochar-nanosilver composite for drinking water purification. Carbohydr. Polym. 2019, 219, 290–297. [Google Scholar] [CrossRef] [PubMed]
- Zhang, J.; Su, P.; Xu, T.; Yuan, L.; Qiao, M.; Yang, B.; Zhao, X. Comprehensive study on the role of reactive oxygen species and active chlorine species on the inactivation and subcellular damage of E.coli in electrochemical disinfection. Sep. Purif. Technol. 2023, 304, 122408. [Google Scholar] [CrossRef]
- Saha, S.; Malik, M.; Qureshi, M. Study of Synergistic Effects of Antibiotics And Triangular Shaped Silver Nanoparticles, Synthesized Using UV-Light Irradiation, on S. Aureus and P. Aeruginosa. Mater. Today Proc. 2019, 18, 920–927. [Google Scholar] [CrossRef]
- Masilan, K.; Neethiselvan, N.; Shakila, R.J.; Muralidharan, N.; Karthy, A.; Ravikumar, T.; Parthiban, F. Investigation on the coacervation of fish scale gelatin hydrogel with seafood waste hydrolysates for the development of artificial fish bait: Physico-chemical, thermodynamic, and morpho-structural properties. J. Indian Chem. Soc. 2022, 99, 100783. [Google Scholar] [CrossRef]
- Zhang, L.; Zheng, S.; Hu, Z.; Zhong, L.; Wang, Y.; Zhang, X.; Xue, J. Preparation of Polyvinyl Alcohol/Bacterial-Cellulose-Coated Biochar–Nanosilver Antibacterial Composite Membranes. Appl. Sci. 2020, 10, 752. [Google Scholar] [CrossRef]
- Thakur, K.; Kalia, S.; Kaith, B.; Pathania, D.; Kumar, A.; Thakur, P.; Knittel, C.E.; Schauer, C.L.; Totaro, G. The development of antibacterial and hydrophobic functionalities in natural fibers for fiber-reinforced composite materials. J. Environ. Chem. Eng. 2016, 4, 1743–1752. [Google Scholar] [CrossRef]
- Bugatti, V.; Zuppardi, F.; Viscusi, G.; Gorrasi, G. Active Packaging Based on Coupled Nylon/PE Pouches Filled with Active Nano-Hybrid: Effect on the Shelf Life of Fresh Milk. Nanomaterials 2021, 11, 1881. [Google Scholar] [CrossRef]
- Bahrami, A.; Mokarram, R.R.; Khiabani, M.S.; Ghanbarzadeh, B.; Salehi, R. Physico-mechanical and antimicrobial properties of tragacanth/hydroxypropyl methylcellulose/beeswax edible films reinforced with silver nanoparticles. Int. J. Biol. Macromol. 2019, 129, 1103–1112. [Google Scholar] [CrossRef] [PubMed]
- Radwan, E.K.; El-Naggar, M.E.; Abdel-Karim, A.; Wassel, A.R. Multifunctional 3D cationic starch/nanofibrillated cellulose/silver nanoparticles nanocomposite cryogel: Synthesis, adsorption, and antibacterial characteristics. Int. J. Biol. Macromol. 2021, 189, 420–431. [Google Scholar] [CrossRef] [PubMed]
- Chen, G.; He, L.; Zhang, P.; Zhang, J.; Mei, X.; Wang, D.; Zhang, Y.; Ren, X.; Chen, Z. Encapsulation of green tea polyphenol nanospheres in PVA/alginate hydrogel for promoting wound healing of diabetic rats by regulating PI3K/AKT pathway. Mater. Sci. Eng. C 2020, 110, 110686. [Google Scholar] [CrossRef] [PubMed]
- Khalaki, M.A.; Moameri, M.; Ghorbani, A.; Alagoz, S.M.; Dolatabadi, N.; Lajayer, B.A.; van Hullebusch, E.D. Chapter 8—Effects, uptake and translocation of Ag-based nanoparticles in plants. In Toxicity of Nanoparticles in Plants; Rajput, V.D., Minkina, T., Sushkova, S., Mandzhieva, S.S., Rensing, C., Eds.; Academic Press: Cambridge, MA, USA, 2022; pp. 171–192. [Google Scholar]
- Jiang, B.; Tian, C.; Song, G.; Pan, Q.; Wang, Z.; Shi, L.; Qiao, Y.; Fu, H. A green route to synthesize novel Ag/C antibacterial agent. Mater. Res. Bull. 2012, 47, 458–463. [Google Scholar] [CrossRef]
- Vityazev, F.V.; Khramova, D.S.; Saveliev, N.Y.; Ipatova, E.A.; Burkov, A.A.; Beloserov, V.S.; Belyi, V.A.; Kononov, L.O.; Martinson, E.A.; Litvinets, S.G.; et al. Pectin–glycerol gel beads: Preparation, characterization and swelling behaviour. Carbohydr. Polym. 2020, 238, 116166. [Google Scholar] [CrossRef] [PubMed]
- Mathew, S.; Jayakumar, A.; Kumar, V.P.; Mathew, J.; Radhakrishnan, E.K. One-step synthesis of eco-friendly boiled rice starch blended polyvinyl alcohol bionanocomposite films decorated with in situ generated silver nanoparticles for food packaging purpose. Int. J. Biol. Macromol. 2019, 139, 475–485. [Google Scholar] [CrossRef] [PubMed]
- Li, Q.; Lu, F.; Zhou, G.; Yu, K.; Lu, B.; Xiao, Y.; Dai, F.; Wu, D.; Lan, G. Silver Inlaid with Gold Nanoparticle/Chitosan Wound Dressing Enhances Antibacterial Activity and Porosity, and Promotes Wound Healing. Biomacromolecules 2017, 18, 3766–3775. [Google Scholar] [CrossRef] [PubMed]
- Li, K.; Zhang, B.; Yang, Z.; Jiang, X.; Li, X. Degradation behaviors of silicone gel encapsulation material with moisture intrusion. Polym. Degrad. Stab. 2022, 206, 110197. [Google Scholar] [CrossRef]
- Aghaei, F.; Tangestaninejad, S.; Bahadori, M.; Moghadam, M.; Mirkhani, V.; Mohammadpoor−Baltork, I.; Khalaji, M.; Asadi, V. Green synthesize of nano-MOF-ethylcellulose composite fibers for efficient adsorption of Congo red from water. J. Colloid Interface Sci. 2023, 648, 78–89. [Google Scholar] [CrossRef] [PubMed]
- Chen, L.; Mi, B.; He, J.; Li, Y.; Zhou, Z.; Wu, F. Functionalized biochars with highly-efficient malachite green adsorption property produced from banana peels via microwave-assisted pyrolysis. Bioresour. Technol. 2023, 376, 128840. [Google Scholar] [CrossRef]

| Dye | qe exp (mg/g) | Pseudo-First-Order Model | Pseudo-Second-Order Model | ||||
|---|---|---|---|---|---|---|---|
| qe cal (mg/g) | k1 (min−1) | R2 | qe cal (mg/g) | k2 (g/mg·min) | R2 | ||
| MB | 6.10 | 5.87 | 1.18 | 0.99 | 6.12 | 0.22 | 0.99 |
| MG | 42.48 | 40.41 | 0.57 | 0.98 | 41.42 | 0.01 | 0.99 |
| MO | 16.42 | 16.03 | 0.94 | 0.98 | 16.68 | 0.05 | 0.99 |
| CR | 17.01 | 17.52 | 0.14 | 0.99 | 17.58 | 0.01 | 0.99 |
Disclaimer/Publisher’s Note: The statements, opinions and data contained in all publications are solely those of the individual author(s) and contributor(s) and not of MDPI and/or the editor(s). MDPI and/or the editor(s) disclaim responsibility for any injury to people or property resulting from any ideas, methods, instructions or products referred to in the content. |
© 2024 by the authors. Licensee MDPI, Basel, Switzerland. This article is an open access article distributed under the terms and conditions of the Creative Commons Attribution (CC BY) license (https://creativecommons.org/licenses/by/4.0/).
Share and Cite
Zhang, Z.; Huang, M.; Shen, K.; He, Y.; Liu, Y. Sodium Alginate–Soy Protein Isolate–Chitosan–Capsaicin–Nanosilver Multifunctional Antibacterial Composite Gel. Processes 2024, 12, 662. https://doi.org/10.3390/pr12040662
Zhang Z, Huang M, Shen K, He Y, Liu Y. Sodium Alginate–Soy Protein Isolate–Chitosan–Capsaicin–Nanosilver Multifunctional Antibacterial Composite Gel. Processes. 2024; 12(4):662. https://doi.org/10.3390/pr12040662
Chicago/Turabian StyleZhang, Zhichao, Meizi Huang, Kejian Shen, Yucai He, and Youyan Liu. 2024. "Sodium Alginate–Soy Protein Isolate–Chitosan–Capsaicin–Nanosilver Multifunctional Antibacterial Composite Gel" Processes 12, no. 4: 662. https://doi.org/10.3390/pr12040662
APA StyleZhang, Z., Huang, M., Shen, K., He, Y., & Liu, Y. (2024). Sodium Alginate–Soy Protein Isolate–Chitosan–Capsaicin–Nanosilver Multifunctional Antibacterial Composite Gel. Processes, 12(4), 662. https://doi.org/10.3390/pr12040662

